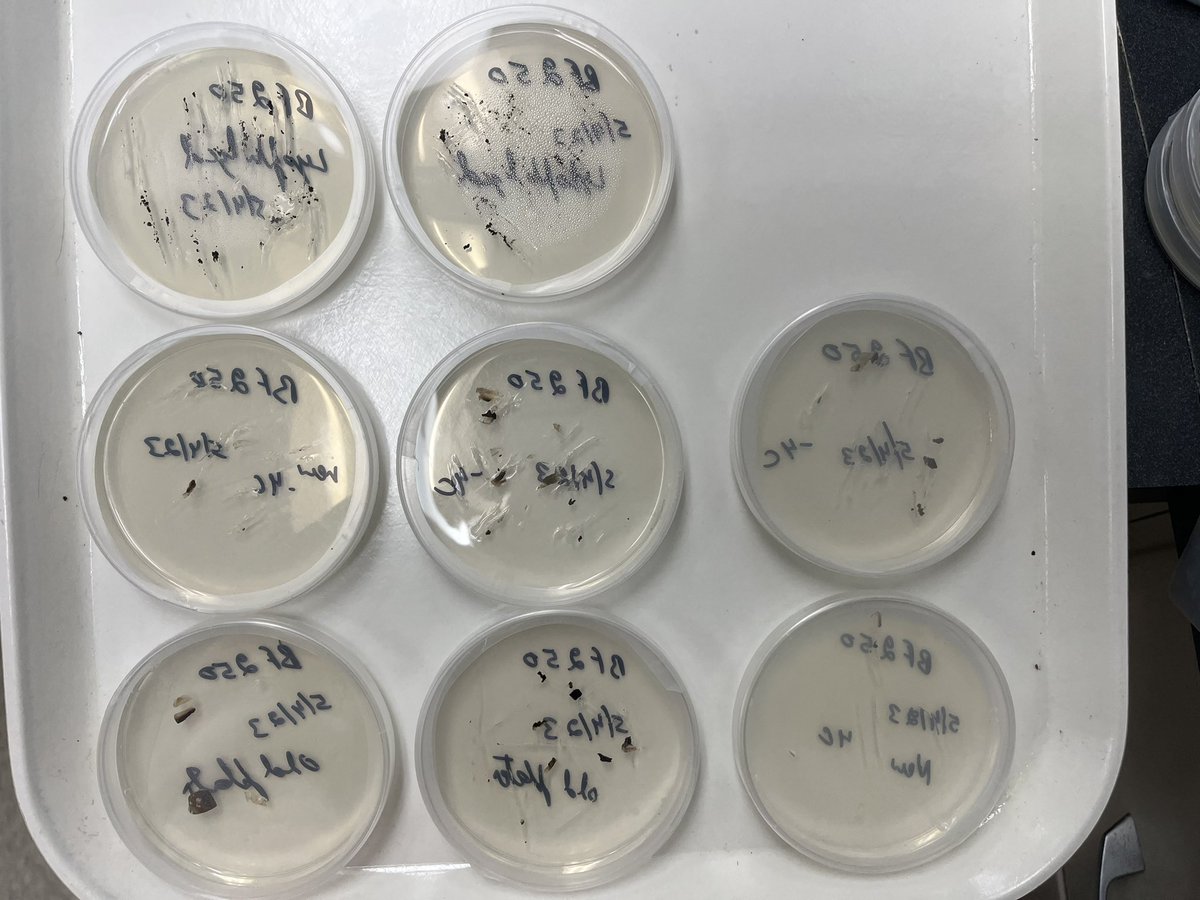

Ava 🌳🔬
@avastallmannmsu
Master's student | Oak wilt management strategies | Michigan State University | Sakalidis Forest Pathology laboratory | that's my brain ⬆️
ID: 1648008627448614912
17-04-2023 17:01:04
20 Tweet
24 Takipçi
31 Takip Edilen

MSU researchers, including Dr. Monique L Sakalidis, Bert Cregg and Deb McCullough, are part of the oak wilt response team. They are looking at novel ways of protecting trees from the deadly pathogen. Michigan Department of Natural Resources MI Ag & Rural Dev Michigan EGLE USDA Forest Service MSU CANR canr.msu.edu/news/msu-resea…

repotting chestnut saplings with Karan Chahal, MS, PhD 🍄🌳🔬🧫🧬🧪🐞 and Ethan! we moved them up from quart-sized to 1.5 gallon pots and loosely staked them to promote straighter growth 🪴







Sakalidis lab #oakwilt field day …do you see the tiny nitidulids in the mycelial mat? #foresthealth #forestpathology MSU-PSM Department MSU AgBioResearch MSU CANR MSU Extension MSU Forestry Karan Chahal, MS, PhD 🍄🌳🔬🧫🧬🧪🐞 Ava 🌳🔬 & Ethan!





Showing preparation of fungal spore suspensions to Ethan, not on Twitter, new MS student in Dr. Monique L Sakalidis lab. He was surprised seeing sporulation potential of #oakwilt fungus in vivo and invitro, good for plant pathologists but sad for oaks!!









From the archives: This appears to be a photograph of the first female packer in the Forest Service, on the Wallowa-Whitman National Forest! The archives unfortunately do not include her name, but we will start digging!